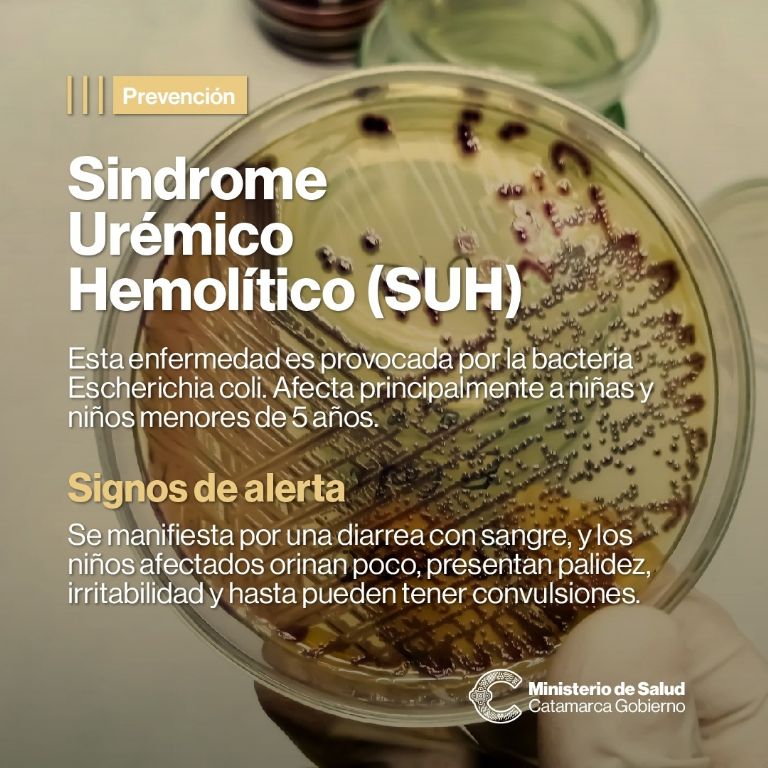

Se trata de una enfermedad grave que afecta generalmente a niños menores de 5 años y se caracteriza por el daño agudo en los riñones, asociado a alteraciones de células de la sangre con reducción de plaquetas, es decir, trombocitopenia, que intervienen en la coagulación y anemia. Los síntomas que pueden presentarse son vómitos, irritabilidad y, en algunos casos, hasta produce convulsiones que muestran el compromiso neurológico, que puede ser de diferente grado; siempre requiere hospitalizaciones y puede llevar a la muerte del paciente. Este cuadro es precedido por síntomas digestivos que pueden aparecer la semana previa, cuyo síntoma más conocido es la diarrea o diarrea con sangre.
El SUH “es producido por la bacteria Escherichia coli a través de una toxina producida por la bacteria responsable de toda la sintomatología”, explicó la licenciada en Nutrición, Priscila Carosella. Esta bacteria está presente en alimentos contaminados, principalmente en carnes crudas, carne picada y alimentos preparados con ellas como hamburguesas, albóndigas, chacinados, etc. “Por esta razón está prohibida la ingesta de alimentos preparados con carne picada en niños menores de cinco años”, continuó Carosella. Esta bacteria también puede estar presente en frutas, como por ejemplo la frutilla, y verduras, sobre todo las de hojas, y que muchas veces se consumen crudas; en el agua contaminada; en lácteos no pasteurizados y de persona a persona por el contacto con manos contaminadas. Sobre las medidas preventivas, la más importante es el lavado de manos con abundante agua y jabón previo a cualquier práctica, especialmente antes de cocinar. Además, la Nutricionista, recalcó la importancia de “cocinar completamente las carnes a una temperatura mayor a 72 grados. Lavado de manos antes y después de preparar los alimentos, y uso de utensilios específicos para la preparación de carne y para la preparación de otros alimentos con otros utensilios. Asimismo, Priscila Carosella hizo hincapié en que los menores de 5 años NO deben consumir carnes picadas o molidas, ni siquiera las picadas en el hogar; tampoco consumir lácteos y jugos no pasteurizados.
- No ingerir carnes mal cocidas.
- Niños menores de 5 años no deben consumir carne picada ni alimentos a base de carne picada; ni embutidos (especialmente salchicha, morcilla y chorizo).
- No consumir jugos ni lácteos que no estén pasteurizados.
- Lavar las manos con abundante agua segura y jabón: Antes, durante y después de preparar alimentos (en especial después de tocar carne cruda). Antes de preparar mamaderas y al alimentar al bebé. Luego de ir al baño, acompañar al niño al baño y después de cambiar pañales. Después de jugar o trabajar con animales.
- Lavar con abundante agua y detergente las tablas y utensilios que usaste para la carne cruda.
- Mantener limpias las esponjas y trapos.
- Mantener las superficies limpias y desinfectadas.
- Lavado de frutas y verduras de forma minuciosa, especialmente las que se van a consumir crudas; con preparación de agua con lavandina (dos gotas de lavandina por cada litro de agua). • Guardar las carnes en la heladera en un envase hermético, alejada del resto de los alimentos.